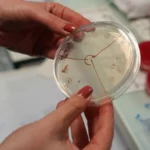

A Liverpool játékosa, Szoboszlai Dominik neve egyre gyakrabban merül fel az európai topklubok átigazolási listáján. A magyar válogatott csapatkapitánya iránt a Real Madrid konkrét érdeklődést mutat, miután Carlo Ancelotti többször is kifejezte elismerését a középpályás teljesítményével kapcsolatban – értesült a Nagymagyarország.com.
A Liverpool vezetősége nehéz helyzetben van, hiszen a 24 éves játékos jelenlegi szerződése 2028-ig szól, azonban a madridi klub komoly ajánlatot készül tenni. A Mersey-partiak számára kulcsfontosságú Szoboszlai megtartása, különösen miután a középpályás az elmúlt szezonban bizonyította értékét az angol élvonalban. Az Angol Labdarúgó-szövetség (FA) szabályzata szerint január 1-jétől már tárgyalásokat kezdeményezhetnek a külföldi klubok.
„Szoboszlai kiváló játékos, aki nemcsak technikai képességeivel, hanem mentalitásával is kiemelkedik. Ilyen játékosokra minden nagy csapatnak szüksége van” – nyilatkozott nemrég Ancelotti egy sajtótájékoztatón. A Liverpool edzője, Arne Slot azonban határozottan kijelentette: „Dominik a projektünk kulcsszereplője, és mindent megteszünk, hogy hosszú távon is nálunk maradjon.”
A helyzetet bonyolítja, hogy a spanyol bajnok mellett más klubok is figyelemmel kísérik a magyar játékos helyzetét. Szoboszlai jelenlegi fizetése évi 6 millió font körül mozog, amit a Real Madrid akár dupláját is kínálhatna. A Liverpool már dolgozik egy új szerződésen, amely jelentős béremelést tartalmazna.
A Magyar Labdarúgó-szövetség (MLSZ) számára is kiemelt jelentőségű, hogy a válogatott csapatkapitánya milyen szinten folytatja pályafutását. Szoboszlai teljesítménye nemcsak hazánk futballjának megítélését befolyásolja, de inspirációt jelent a fiatal magyar játékosok számára is. Az átigazolási spekulációk várhatóan a januári átigazolási időszak közeledtével tovább erősödnek.